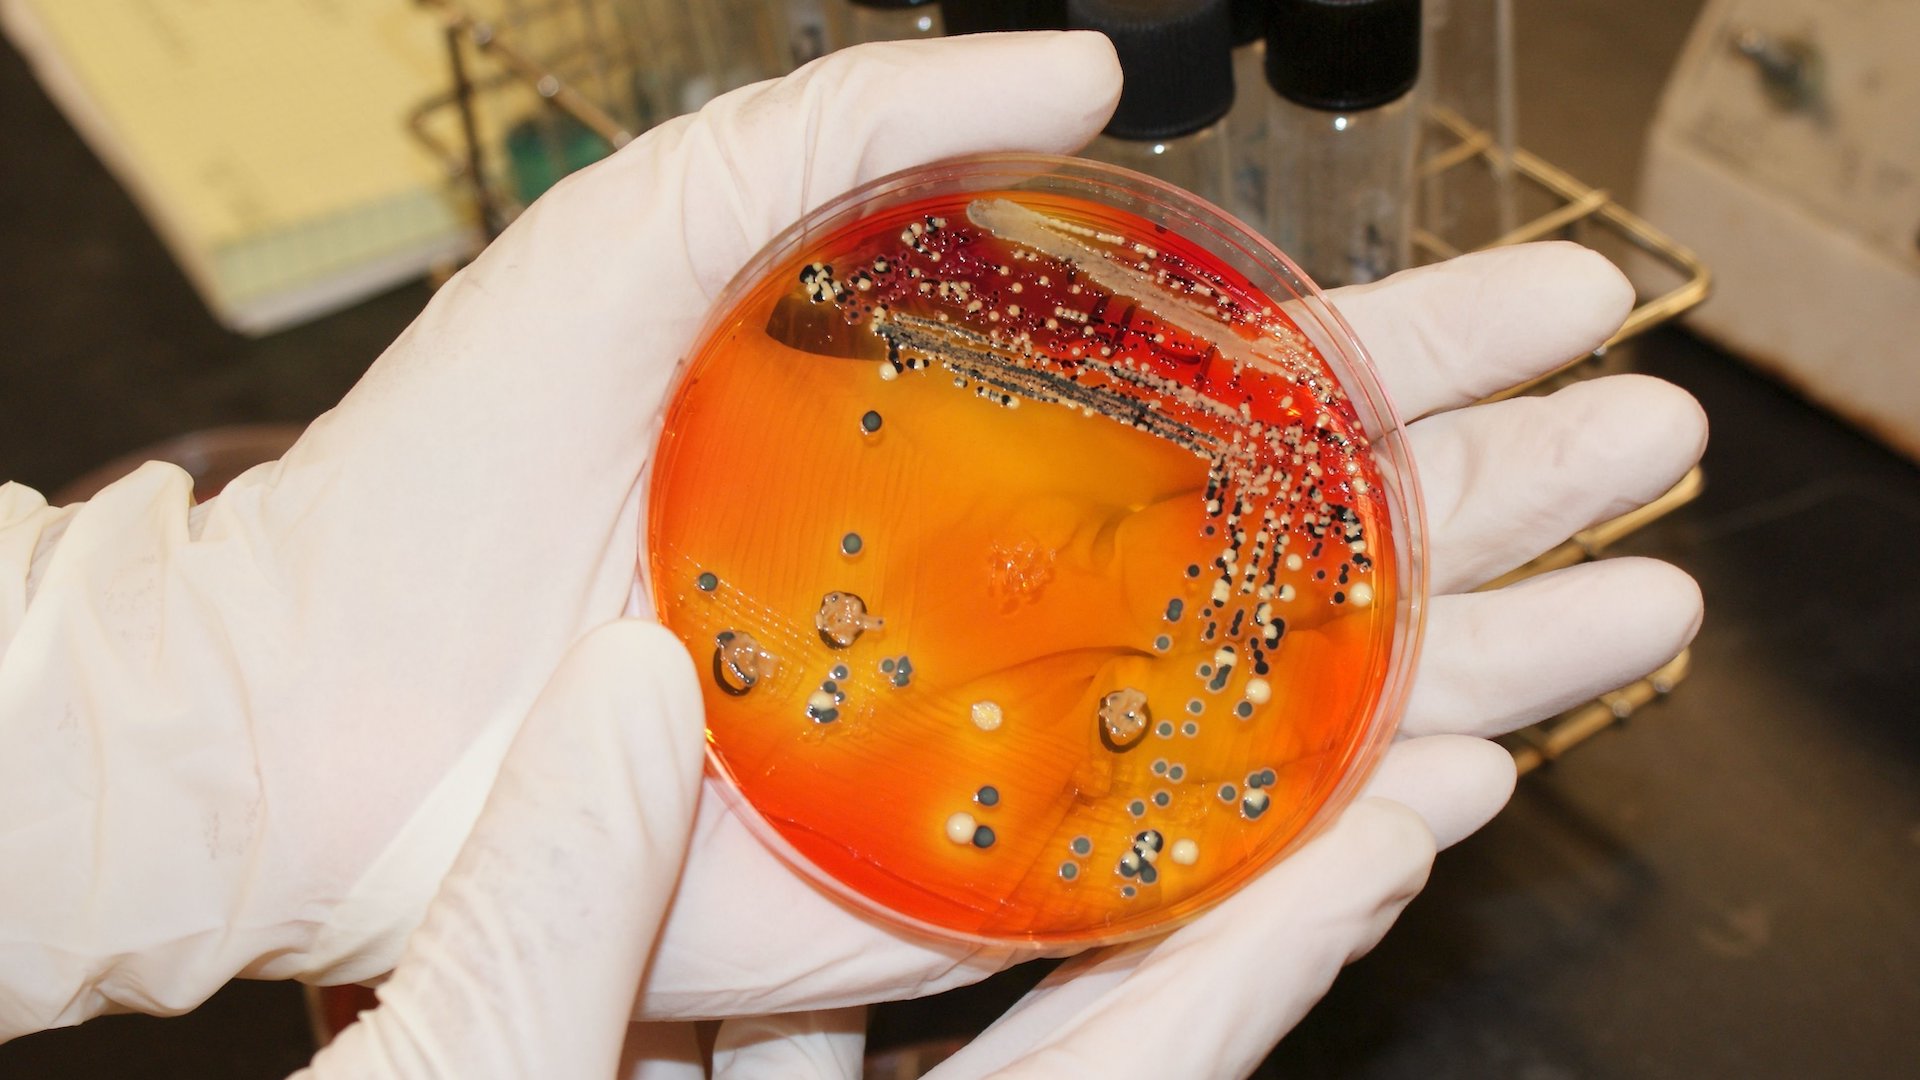

Netušíš, čo v nich skutočne je. Pred Veľkou nocou Slovensko zaplavujú „čierne“ pochúťky
- Na Slovensku sa rozmáha nelegálny biznis
- Čierny predaj zákuskov, koláčov a toriet počas Veľkej noci rastie

Veľkonočné sviatky sú časom radosti, rodinného stretávania a tradičných zvykov. Pre niektorých však predstavujú aj príležitosť na nekalé praktiky. Čierny predaj zákuskov je v poslednej dobe výrazne narastajúcim problémom v mnohých krajinách.
Podľa informácií TASR sa čierny predaj koláčov, zákuskov a toriet, ktoré sa vyrábajú v neregistrovaných potravinárskych prevádzkach, rozmáha na Slovensku čoraz viac.
Neznáme suroviny a podmienky
O čiernom predaji informoval predseda predstavenstva Slovenského zväzu pekárov, cukrárov a cestovinárov (SZPCC) Milan Lapšanský.
„Veľká noc je obdobím tradičných zákuskov a koláčov, ktoré na stoloch slovenských gazdiniek nemôžu chýbať a ani muži, šibači, si bez nich tieto sviatky nevedia predstaviť. Upozorňujeme však spotrebiteľov, aby zvýšili opatrnosť pri ich nákupe z neznámych zdrojov,“ uviedol Lapšanský.
„Najmä na internete sa totiž čoraz viac rozširuje predaj týchto výrobkov vyrobených z neznámych surovín a v podmienkach, ktoré nikto nedokáže skontrolovať, keďže ide o nelegálne prevádzky. Štátne orgány ich nevedia zachytiť a neraz ohrozujú zdravie spotrebiteľov,“ spresnil Lapšanský.
Bez kontroly
Podľa zákona musí byť na Slovensku výrobca a predajca zákuskov, koláčov či toriet registrovaný ako potravinárska prevádzka. Tým podlieha prísnym hygienickým pravidlám a kontrolujú ho aj štátne orgány. Zoznam schválených/registrovaných potravinárskych prevádzkarní si môžeš pozrieť na webovej stránke Štátnej veterinárnej a potravinovej správy SR.
Vstupné suroviny a aj výrobky má mať prevádzka kontrolované a pochádzať majú iba z výhradne legálnych zdrojov. Okrem toho svoje produkty tiež pravidelne kontroluje na mikrobiologickú bezpečnosť v akreditovaných laboratóriách.
Nelegálne prevádzky však nekontroluje nikto. Suroviny, ktoré používajú, sú často iba cieľom rýchleho zisku, nespĺňajú zdravotné kritériá či minimálne štandardy. Využívajú suroviny, ako napríklad prídavné látky či farbivá z Ázie, ktoré sú pre trh EÚ neschválené a navyše nespĺňajú európske kvalitatívne štandardy.
Závažné dôsledky
Spotrebitelia si často takéto výrobky objednávajú prostredníctvom internetu. Podľa Lapšanského sa tak vystavujú vážnym zdravotným rizikám od salmonely cez E. coli až po rôzne plesňové ochorenia. Tie spôsobujú zvracania, hnačky, v niektorých prípadoch aj trvalé následky pri použití ingrediencií, ktoré obsahujú ťažké kovy.
V extrémnych prípadoch môžu tieto nevyhovujúce výrobky zapríčiniť dokonca aj smrť. Pri prípadnom poškodení zdravia však nie je možné brať nelegálnu prevádzku na zodpovednosť.
„Registrované cukrárske prevádzky prechádzajú pravidelne dôslednými kontrolami štátnych orgánov a sú neustále pod ich drobnohľadom. Pozorne si vyberajú suroviny na výrobu zákuskov, koláčov a toriet. Zároveň dodržujú všetky hygienické postupy a normy, a aj preto sa možno niekedy zdajú ich výrobky drahšie,“ uviedol Lapšanský.
„Treba si však uvedomiť, že odvádzajú dane, platia zamestnancov, dodržujú hygienické pravidlá a nemôžu si dovoliť svojich zákazníkov oklamať, pretože by im to okamžite zničilo ich živobytie. Spotrebitelia by mali preto venovať najmä pred sviatkami viac pozornosti tomu, odkiaľ zákusky a koláče na ich stoloch pochádzajú,“ dodal Lapšanský.
Čítaj viac z kategórie: Hlavné správy a aktuality











